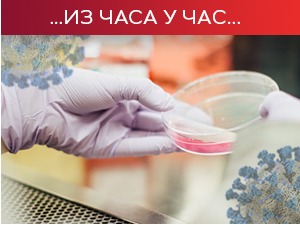
Преминуло још 30 пацијената, коронавирусом заражено још 1.987 особа

Коронавирус у Србији
уторак, 27. апр 2021, 06:00 -> 11:44
Сутра седница Кризног штаба – вакцинација "Фајзером", "спутњиком" и Синофармом" без заказивања
До сада су у Србији регистрована 681.654 случаја коронавируса, а од последица ковида 19 преминуло је 6.257 особа. Проценат смртности је 0.92 одсто. Од почетка епидемије тестирано је 3.787.020 узорака...
понедељак, 26. апр 2021, 15:00 -> 15:30
Преминуло још 30 пацијената, коронавирусом заражено још 1.987 особа
У Србији је у последња 24 сата потврђено 1.987 нових случајева коронавируса, на основу 11.657 тестираних узорака. Од последица ковида 19 преминуло је 30 особа. На болничком лечењу налази се 5.318 особа...
понедељак, 26. апр 2021, 12:50 -> 13:48
Брнабић: Радимо наше, а пратимо детаљно и светске студије о вакцинама
Премијерка Ана Брнабић изјавила је да се у Србији раде студије о евентуалној трећој дози кинеског "Синофарма", али и да се детаљно прате и све друге светске студије о томе, те да ће се поступити у складу...
понедељак, 26. апр 2021, 12:08 -> 12:20
Лончар: Више од 99 одсто хоспитализованих није вакцинисано
На болничком лечењу тренутно се налази 5.607 пацијената, а више од 99 одсто њих није вакцинисано, изјавио је за "Танјуг" министар здравља Златибор Лончар...
понедељак, 26. апр 2021, 11:40 -> 12:04
Деветогодишње дете преминуло у Нишу од последица коронавируса
Деветогодишњи дечак Д. П. из Врања, који је 8. априла примљен на Клинику за дечије интерне болести Универзитетског клиничког центра Ниш, због обостране упале плућа и потврђене ковид инфекције, преминуо...
понедељак, 26. апр 2021, 08:21 -> 09:08
Од сутра без заказивања и "Синофарм" вакцина
Директор Канцеларије за е-Управу Михаило Јовановић каже за РТС да ће од сутра на свим вакциналним пунктовима широм Србије бити омогућено вакцинисање без заказивања са три вакцине – "Фајзер", "спутњик В"...
понедељак, 26. апр 2021, 06:00 -> 06:20
Хронични хепатитис, болести јетре – да ли пацијенти са овим болестима треба да приме вакцину
Средином недеље требало би да број вакцинисаних макар једном дозом пређе два милиона. Стучњаци решавају нове дилеме у вези са вакцинацијом...
понедељак, 26. апр 2021, 06:00 -> 12:21
Стигао нови контингент вакцине "Синофарм", од сутра вакцинација без заказивања са три вакцине
На болничком лечењу је тренутно 5.601 пацијент, од којих су 202 на респиратору. Проценат позитивних међу тестиранима полако пада, али надлежни апелују да не сме доћи до опуштања и да мере морају да се...
недеља, 25. апр 2021, 15:00 -> 16:21
Преминуо још 31 пацијент, коронавирусом заражено још 1.695
У Србији су, према последњим подацима, битку са ковидом изгубила 31 пацијент. Потврђена су 1.695 нова случаја заразе од 8.956 тестираних узорака...
недеља, 25. апр 2021, 08:38 -> 15:50
Ђерлек за РТС: Мере вероватно остају исте, још два до три месеца и близу смо циља
Државни секретар Министарства здравља Мирсад Ђерлек каже за РТС да бројке јесу добре, али поручује грађанима да издрже још мало, да нема места опуштању и да се придржавају мера, које ће вероватно остати исте...

Коментари